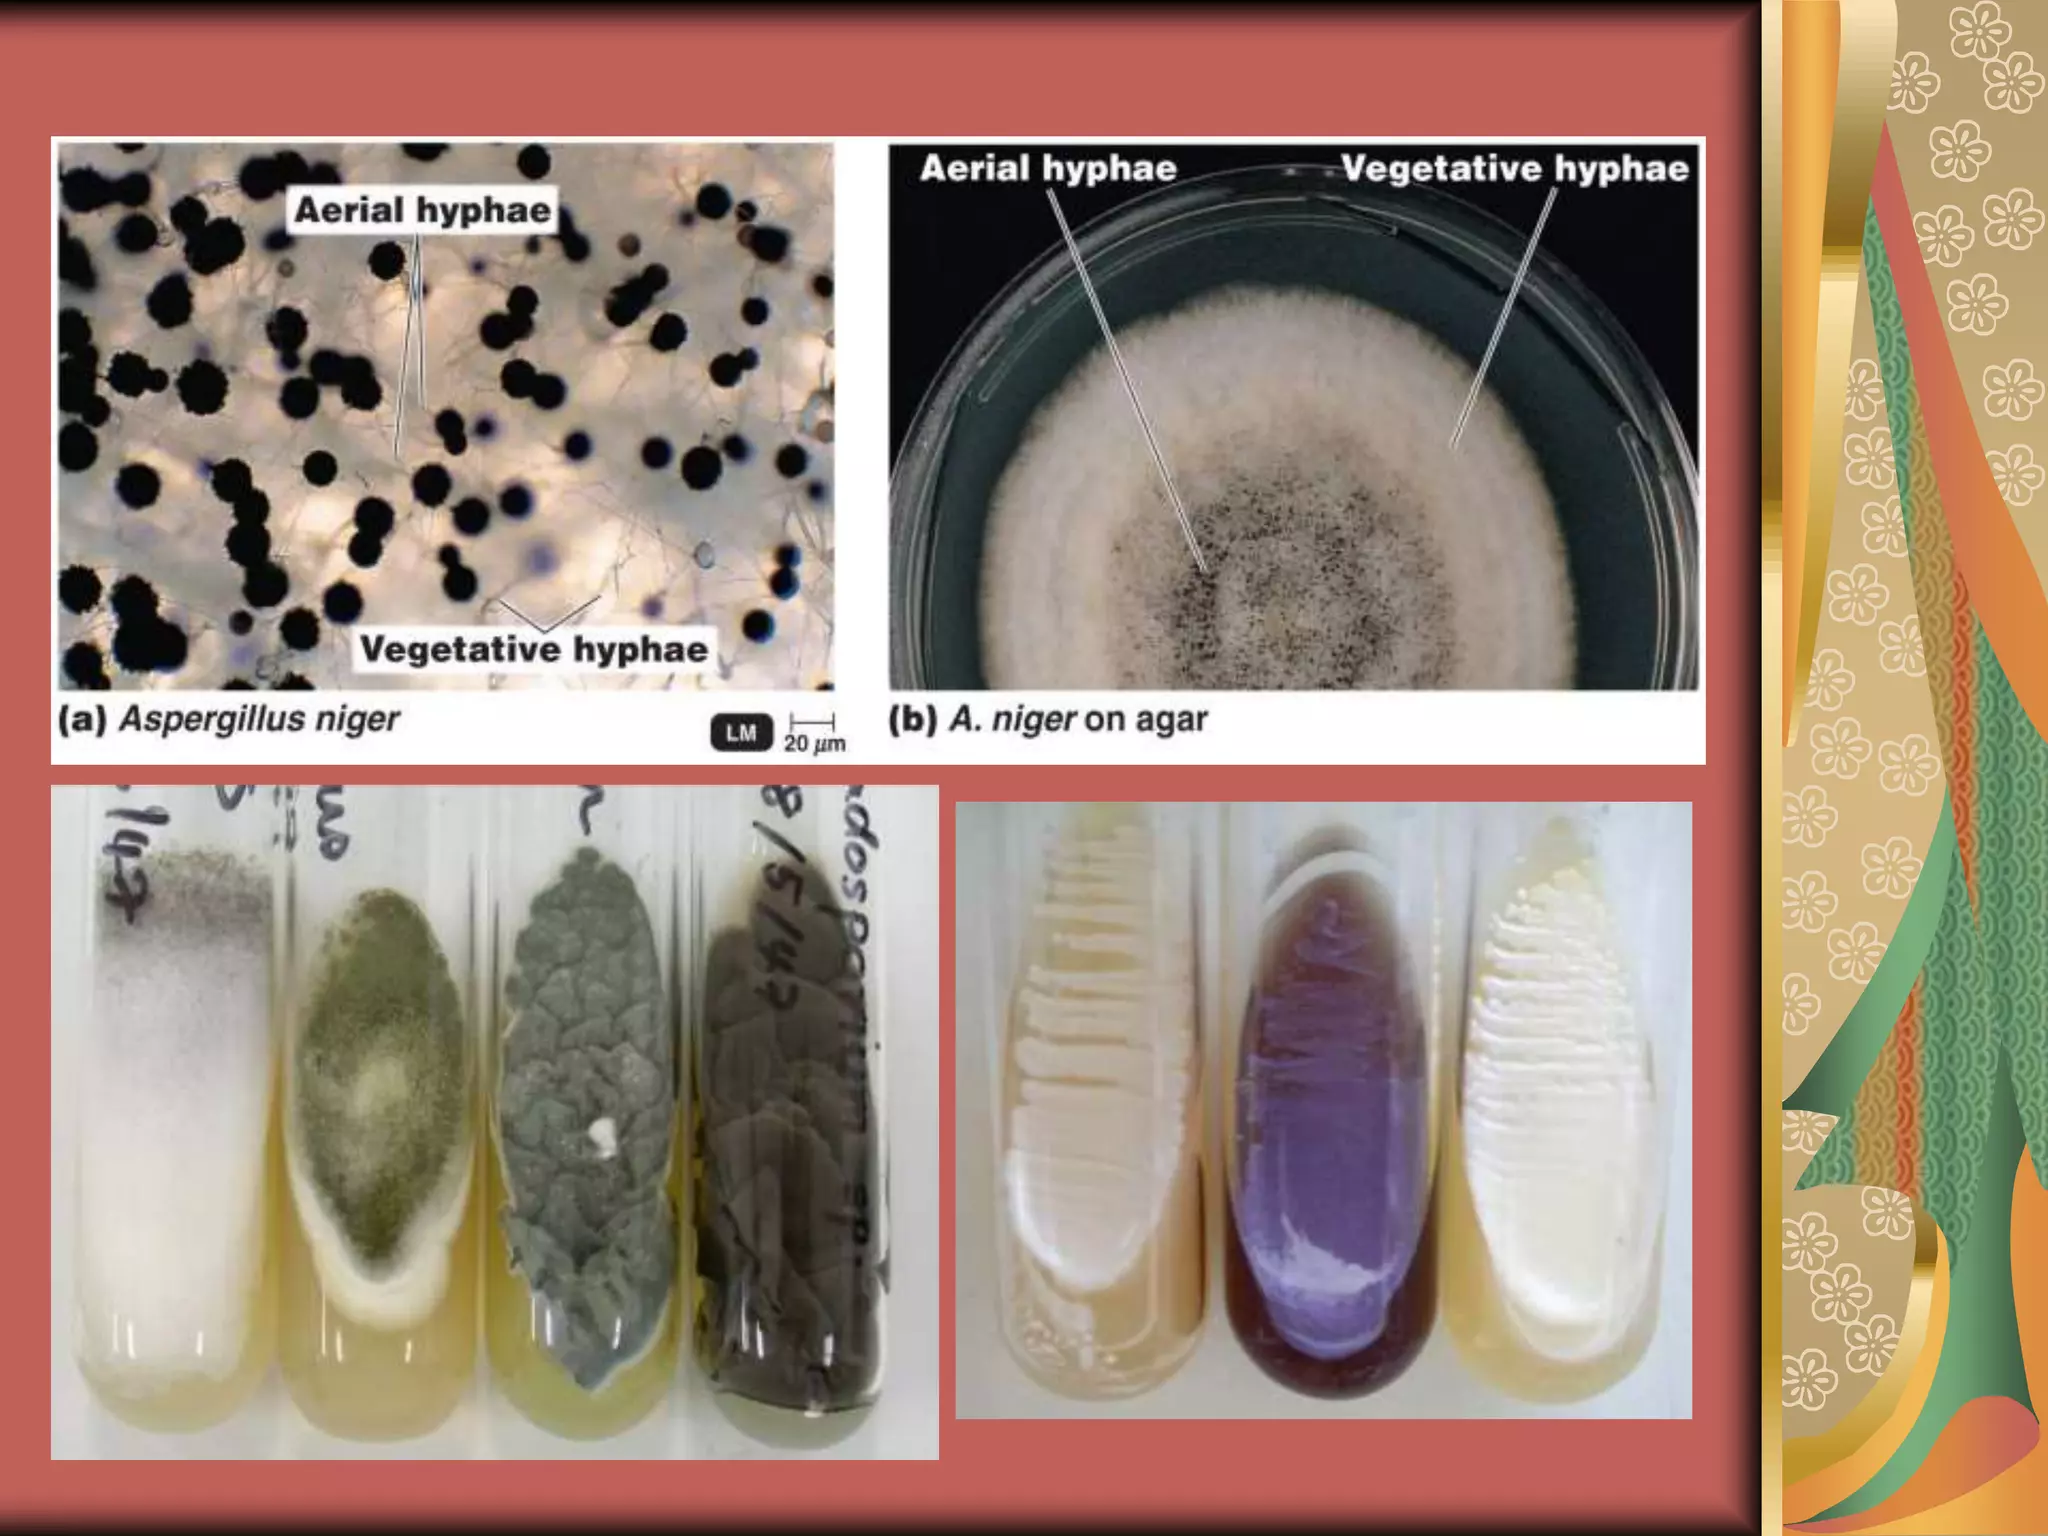

Fungi can reproduce both sexually and asexually. Asexual reproduction occurs through spores produced in structures called sporangia or gametangia. Spores come in different shapes and sizes, and some are dry while others are slimy. Dry spores can travel distances as far as 2 meters from their origin by exploding out of the sporangium. Slimy spores adhere to the bodies of insects and other arthropods to aid in dispersal. Common modes of asexual reproduction include budding, binary fission, fragmentation of hyphae, and production of mitospores like zoospores, sporangiospores, and conidia.